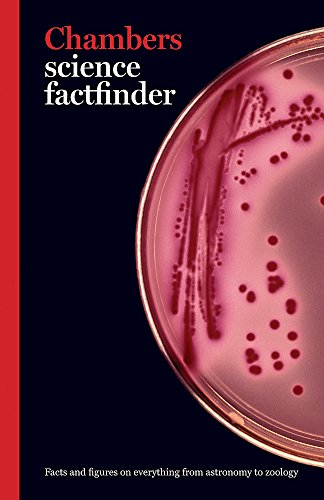
Chambers Science Factfinder

Chambers Science Factfinder
Chambers Science Factfinder
Regular price
Checking stock...
Regular price
Checking stock...
Summary
An entertaining and informative guide to the world of science
The feel-good place to buy books
- Free delivery in Ireland
- Supporting authors with AuthorSHARE
- 100% recyclable packaging
- Proud to be a B Corp – A Business for good
- Buy-back with Ziffit

Chambers Science Factfinder by Editors Of Chambers
Philip Ball makes physics sexy again Vanity Fair Chambers Science Factfinder provides an engaging and accessible introduction to a broad range of scientific topics, from diseases and medicines to climate and environment. It offers straightforward explanations of notable principles, equations and laws, ranging from quantum theory to natural selection. Intriguing facts, illuminating quotations and ingenious scientific techniques are scattered throughout the text, making it perfect for browsing as well as for reference; illustrations and diagrams add to the book's appeal. Ideal for young people and adults alike, Chambers Science Factfinder will entertain as well as inform.
Philip Ball makes physics sexy again - Vanity Fair
Chambers is one of the world's most respected dictionary publishers, appealing particularly to word lovers and those who revel in all the quirks of the English language. Its extensive list of innovative language and reference titles includes the renowned Brewer's list of endlessly browsable dictionaries of phrase and fable, and covers English-language dictionaries and thesauruses for every level of user from school to crossword fan, from English learner to student of slang. Meticulously researched and expertly written, the highly acclaimed Chambers range has been at the forefront of presenting knowledge and learning in an engaging and accessible way since it was first established in the 19th century.Chambers is one of the world's most respected dictionary publishers, appealing particularly to word lovers and those who revel in all the quirks of the English language. Its extensive list of innovative language and reference titles includes the renowned Brewer's list of endlessly browsable dictionaries of phrase and fable, and covers English-language dictionaries and thesauruses for every level of user from school to crossword fan, from English learner to student of slang. Meticulously researched and expertly written, the highly acclaimed Chambers range has been at the forefront of presenting knowledge and learning in an engaging and accessible way since it was first established in the 19th century.
| SKU | Unavailable |
| ISBN 13 | 9780550101488 |
| ISBN 10 | 0550101489 |
| Title | Chambers Science Factfinder |
| Author | Editors Of Chambers |
| Condition | Unavailable |
| Binding Type | Paperback |
| Publisher | John Murray Press |
| Year published | 2006-04-28 |
| Number of pages | 544 |
| Cover note | Book picture is for illustrative purposes only, actual binding, cover or edition may vary. |
| Note | Unavailable |